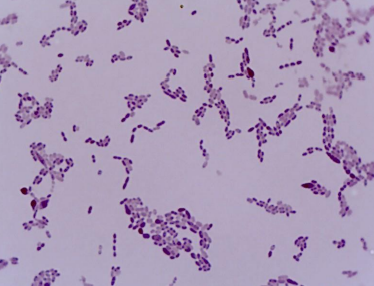
<p>PATHOGENIC BACTERIA:</p>
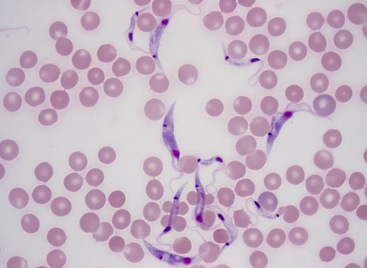
<p>PATHOGENIC PROTISTS:</p>
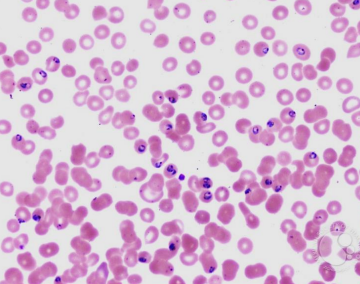
<p>PATHOGENIC PROTISTS:</p>

1/28
Looks like no tags are added yet.
Name | Mastery | Learn | Test | Matching | Spaced | Call with Kai |
|---|
No analytics yet
Send a link to your students to track their progress
Pos. Presumptive ferment test
water sample might contain fecal coliforms
1/10=
0.1 = 10-^1
1/100=
0.01= 10-^2
1/1000=
0.001=10-^3
1/10000=
0.0001=10-^4
MPN
Most Probable Number
The definition of Fecal Coliforms is:
Gram - neg, Rob- shape, Ferment lactose, Produce acid, No endospores
Fecal coliform has turned pink on this agar. What is the name of this agar?
MacConkey

PATHOGENIC BACTERIA:
Bacillus anthracis, respiratory disease

PATHOGENIC BACTERIA:
Neisseria gonorrhoeae, disease gonorrhea

PATHOGENIC BACTERIA:
Treponema pallidum, disease syphilis

PATHOGENIC BACTERIA:
Corynebacterium diphtheriae, disease diphtheria

PATHOGENIC BACTERIA:
Clostridium, Cdiff

PATHOGENIC BACTERIA:
Staphylococcus aureus, disease MRSA
PATHOGENIC BACTERIA:
Streptococcus pneumoniae, disease pneumonia

PATHOGENIC PROTISTS: (diarrhea w/ blood)
Entamoeba histolytica, disease amoebic dysentery

PATHOGENIC PROTISTS:
Balantidium coli, disease balantidial dysentery
PATHOGENIC PROTISTS:
Trypanosoma, disease sleeping sickness
PATHOGENIC PROTISTS:
Plasmodium, disease malaria
Pasteurization
do not kill ALL bacteria (classic, HTST, UHT)
Pasteurization- CLASSIC
High temp, short time; 145F 30mins
Pasteurization- HTST
161F 15secs
Pasteurization- UHT (ultra high temp)
284F 3secs
Autoclave
250F 15mins Kills ALL bacteria (sterile)

autoclave tape
non-sterilized (top) and sterilized (bottom).

Endospore stain of Bacillus
endospores-GREEN dots and vegetative cells-PINK/RED cells.

For Endospore Stain what was used?
Malachite green
For vegetative cells what was used?
safranin

__
Bacillus